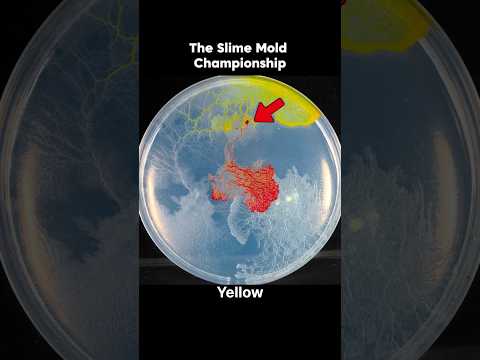

Channel Overview
QuirkLab, a top YouTuber from United States of America, boasts 312.0K subscribers, 208.5M views and ranks #125231 globally and #23398 in United States of America. Dominating the Howto & Style category. The channel recently hit 66.8M views in last 28 days.
- Channel:QuirkLab
- Subscribers:312.0K
- Views:208.5M
- Videos:453
- Category:Howto & Style
- Country:United States of America
- 28 days views:66.8M
- Country (US) Rank:#23398
- Global Rank:#125231
QuirkLab Channel Stats
Updated: 11 Apr
312.0K
208.5M
689
453
(
+1
)460.3K
Howto & Style
1 year ago
4
Advanced Analytics
Channel Daily Performance
Channel Videos
Trending Videos
QuirkLab Channel Rank
Subscribers
312,000
Views
208,513,722
Subs (28 Days)
Views (28 Days)
QuirkLab Latest Videos

00:55
Slime Mold PK Battle PART.3
QuirkLab
138.4K
+50.1K
4.0K
4 Apr 2026

01:00
How the Bombardier Beetle Repels Predators with 100°C Sprays?
QuirkLab
2.7M
+462.9K
73.6K
4 Apr 2026

00:56
Slime Mold PK Battle PART.2
QuirkLab
300.9K
+66.0K
8.1K
3 Apr 2026
00:56
Slime Mold PK Battle
QuirkLab
205.5K
+8.4K
4.8K
2 Apr 2026

01:07
Slime Mold Taste Experiment
QuirkLab
446.2K
+18.2K
15.4K
1 Apr 2026
QuirkLab Latest Trending Videos


